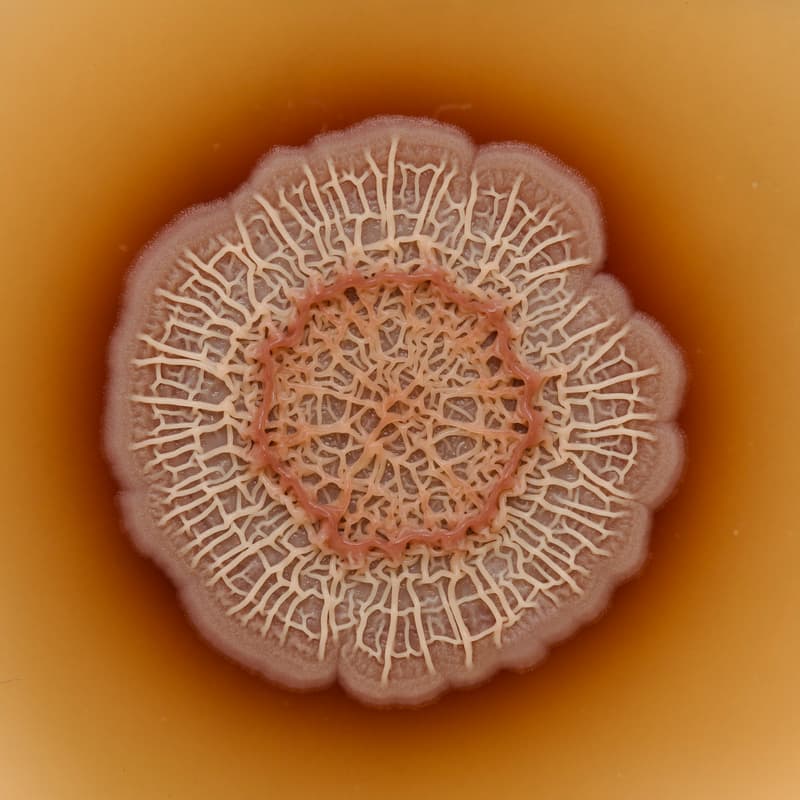
Cover Image for Meet the Microbes: Inside Andes' Carbon Dioxide Removal Science (+Pastries)

Featured in
SF Climate Week 2026
Meet the Microbes: Inside Andes' Carbon Dioxide Removal Science (+Pastries)
Hosted by Julianna Werffeli & 3 others
Registration
Approval Required
Your registration is subject to host approval.
About Event
🔬 Meet the Microbes: Inside Andes’ Carbon Dioxide Removal Science
We’re opening the doors to our Alameda facility for a behind-the-scenes look at the science powering our microbial carbon dioxide removal technology, designed to work with nature, support farmers, and durably remove CO₂ from the atmosphere.
Join us for a tour of our facility, meet members of our team, and get an inside look at how our microbes are turning cropland into a climate solution.
We'll have pastries after!
Learn more at andes.bio
By registering for this event, you agree to share your registration information with the organizers of SF Climate Week.